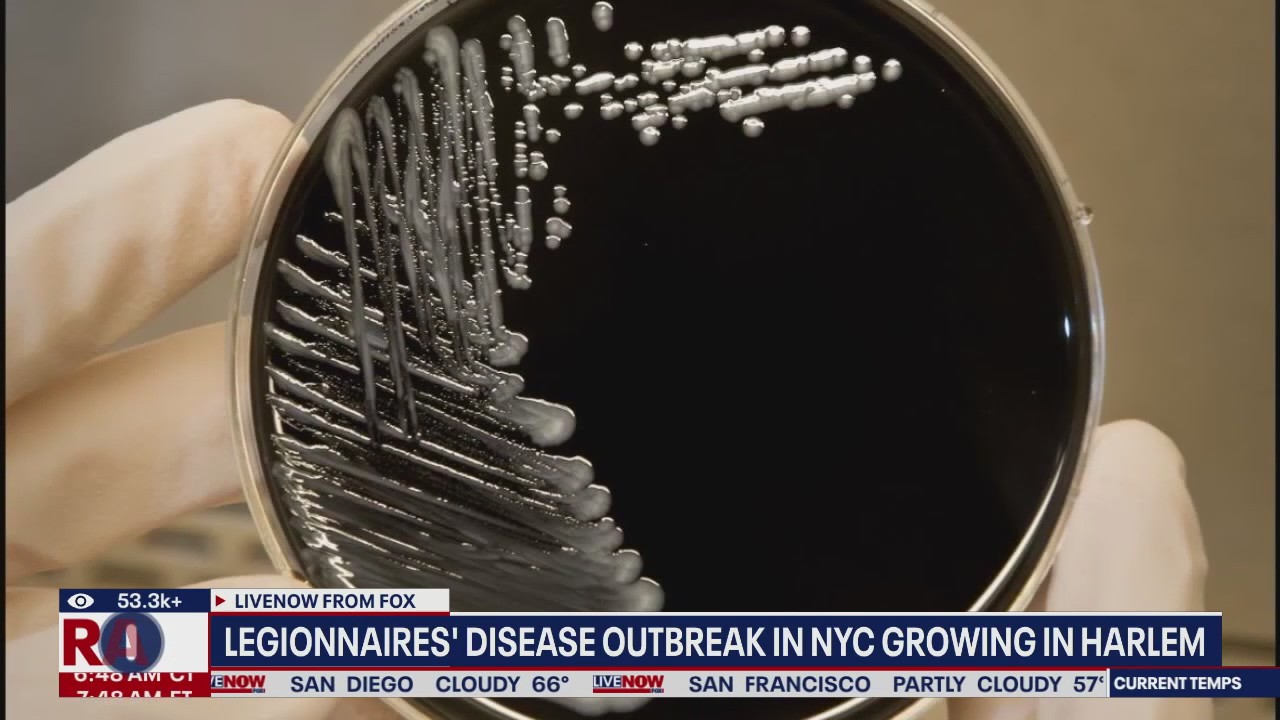
Legionnaires' Disease outbreak in NYC growing in Harlem

Canyon Fire burns 1,000+ acres in L.A. area
Amid high heat, a brush fire broke out near Lake Piru in Ventura County Thursday afternoon.
Amid high heat, a brush fire broke out near Lake Piru in Ventura County Thursday afternoon.
Soldiers honored for stopping Fort Stewart shooter
The Army awarded six soldiers for their acts of heroism at Fort Stewart during a shooting at the base. Secretary of the Army Dan Driscoll said one of the soldiers tackled the alleged shooter, a U.S. Army Sergeant.
The Army awarded six soldiers for their acts of heroism at Fort Stewart during a shooting at the base. Secretary of the Army Dan Driscoll said one of the soldiers tackled the alleged shooter, a U.S. Army Sergeant.
PA deadly shooting: Woman killed, troopers ambushed
Officials in Pennsylvania provided new information about a deadly shooting in Susquehanna County. A woman was shot and killed by her neighbor before two Pennsylvania state troopers were "ambushed by rifle fire" while responding to the shooting.
Officials in Pennsylvania provided new information about a deadly shooting in Susquehanna County. A woman was shot and killed by her neighbor before two Pennsylvania state troopers were "ambushed by rifle fire" while responding to the shooting.
Kelly Clarkson's ex-husband, Brandon Blackstock dies
Brandon Blackstock has died at the age of 48. He was the former manager and ex-husband to Kelly Clarkson. We are learning the latest with LiveNOW?s Andy Mac and TMZ?s Branson Quirke.
Brandon Blackstock has died at the age of 48. He was the former manager and ex-husband to Kelly Clarkson. We are learning the latest with LiveNOW?s Andy Mac and TMZ?s Branson Quirke.
Canyon fire near LA county prompts evacuation warning
A wildfire called the Canyon fire is spreading across Ventura County and into Los Angeles prompting evacuation warnings for several areas nearby. This 30 acre fire is burning near Santa Clarita by Lake Piru in Southern California.
A wildfire called the Canyon fire is spreading across Ventura County and into Los Angeles prompting evacuation warnings for several areas nearby. This 30 acre fire is burning near Santa Clarita by Lake Piru in Southern California.
Rep. Nancy Mace on her run for SC Governor
Earlier this week, Republican Rep. Nancy Mace launched her bid to become the next Governor of the Palmetto State. Rep. Mace has previously called out "weak leadership" in the state and said it is one of the reasons behind her run. Andy Mac had the chance to speak to the Congresswoman in an exclusive interview with LiveNOW.
Earlier this week, Republican Rep. Nancy Mace launched her bid to become the next Governor of the Palmetto State. Rep. Mace has previously called out "weak leadership" in the state and said it is one of the reasons behind her run. Andy Mac had the chance to speak to the Congresswoman in an exclusive interview with LiveNOW.
President Trump honors 100 purple heart recipients
President Trump held an event at the White House to honor 100 Purple Heart recipients. During this event Trump was joined by three men who gifted him their medals after the July 2024 assassination attempt in Pennsylvania
President Trump held an event at the White House to honor 100 Purple Heart recipients. During this event Trump was joined by three men who gifted him their medals after the July 2024 assassination attempt in Pennsylvania
'Only took one puff': Passenger caught vaping in bathroom of SF-bound flight
Peter Nguyen recorded the Aug. 4 encounter between himself and a flight attendant on American Airlines Flight 2860 from Phoenix to San Francisco International Airport. He claimed he only took one hit of his vape.
Peter Nguyen recorded the Aug. 4 encounter between himself and a flight attendant on American Airlines Flight 2860 from Phoenix to San Francisco International Airport. He claimed he only took one hit of his vape.
"I am you!" says NYC Mayor Eric Adams
At a campaign event in New York City for mayor, current Mayor Eric Adams spoke about why he should be elected for mayor in New York this year for the coming term.
At a campaign event in New York City for mayor, current Mayor Eric Adams spoke about why he should be elected for mayor in New York this year for the coming term.
Two Pennsylvania state troopers shot, suspect killed in Susquehanna County: PSP
Two Pennsylvania state troopers were shot in Susquehanna County on Thursday afternoon, according to Gov. Josh Shapiro, who broke the news during an event in Bucks County.
Two Pennsylvania state troopers were shot in Susquehanna County on Thursday afternoon, according to Gov. Josh Shapiro, who broke the news during an event in Bucks County.
President Trump makes major economic announcement
President Trump called reporters into the Oval Office to make a "major" economic announcement. President Trump presented new economic data alongside Stephen Moore from the Heritage Foundation.
President Trump called reporters into the Oval Office to make a "major" economic announcement. President Trump presented new economic data alongside Stephen Moore from the Heritage Foundation.
President Trump's latest tariffs take effect
President Donald Trump is enforcing higher import taxes on goods from more than 60 countries, including the European Union and Japan. Tariffs rates on goods from these countries could be taxed by 10% or more. LiveNOW's Mike Pache spoke about the latest round of tariffs with Rob Schroeder from MarketWatch.
President Donald Trump is enforcing higher import taxes on goods from more than 60 countries, including the European Union and Japan. Tariffs rates on goods from these countries could be taxed by 10% or more. LiveNOW's Mike Pache spoke about the latest round of tariffs with Rob Schroeder from MarketWatch.
Netanyahu: 'take control of Gaza'
Israeli Prime Minister Benjamin Netanyahu said Israel "intends" to take control of Gaza. Netanyahu said Israel wants to end the threat of Hamas' terror regime against his country.
Israeli Prime Minister Benjamin Netanyahu said Israel "intends" to take control of Gaza. Netanyahu said Israel wants to end the threat of Hamas' terror regime against his country.
Israeli embassy shooting: gunman could face death
U.S. Attorney for D.C. Pirro said the gunman was indicted for 9 crimes. He faces hate crimes for the murder of two staffers. Yaron Lischinsky and Sarah Lynn Milgrim were killed in the shooting. Elias Rodriguez was charged with all nine counts resulting in death charges.
U.S. Attorney for D.C. Pirro said the gunman was indicted for 9 crimes. He faces hate crimes for the murder of two staffers. Yaron Lischinsky and Sarah Lynn Milgrim were killed in the shooting. Elias Rodriguez was charged with all nine counts resulting in death charges.
Pres. Trump's Canada tariff fight
Dozens of countries are waking up this morning to higher tariffs. Last week, Trump signed executive orders slapping tariffs between 10% and 41% on a range of countries, but delayed their start date to today. FOX's Kailey Schuyler joined LiveNOW from FOX from Windsor, Canada.
Dozens of countries are waking up this morning to higher tariffs. Last week, Trump signed executive orders slapping tariffs between 10% and 41% on a range of countries, but delayed their start date to today. FOX's Kailey Schuyler joined LiveNOW from FOX from Windsor, Canada.
Fort Stewart update: suspect Quornelius Radford
Fort Stewart officials provided an upate on the shooting that left 5 soldiers wounded. Quornelius Radford is the Army sergeant accused of shooting soldiers in Georgia. The soldiers were shot in the 2nd Armored Brigade Combat Team area of the base, according the the U.S. Army.
Fort Stewart officials provided an upate on the shooting that left 5 soldiers wounded. Quornelius Radford is the Army sergeant accused of shooting soldiers in Georgia. The soldiers were shot in the 2nd Armored Brigade Combat Team area of the base, according the the U.S. Army.
President Trump's rebate check
American families could receive $2,400 from rebate checks. CEO of GMM Monstick Coatings Ravin Gandhi joins LiveNOW from FOX's Christy Matino to answer viewers' questions about tariffs.
American families could receive $2,400 from rebate checks. CEO of GMM Monstick Coatings Ravin Gandhi joins LiveNOW from FOX's Christy Matino to answer viewers' questions about tariffs.
Legionnaires' Disease outbreak in NYC growing in Harlem
The number of deaths and confirmed cases of Legionnaire's Disease, in Harlem, is climbing . FOX 5 New York's, Hayley Fixler, joins LiveNOW from FOX with the latest on this health alert.
The number of deaths and confirmed cases of Legionnaire's Disease, in Harlem, is climbing . FOX 5 New York's, Hayley Fixler, joins LiveNOW from FOX with the latest on this health alert.
2 arrested in $640k identity theft, gold coin scheme
Two people were arrested by D.C. police in connection to a $640,000 gold coin fraud operation.
Two people were arrested by D.C. police in connection to a $640,000 gold coin fraud operation.
President Trump, lawmakers react to GA shooting
President Trump and other lawmakers are reacting to the shooting that left 5 soldiers injured at Fort Stewart in Georgia Wednesday.
President Trump and other lawmakers are reacting to the shooting that left 5 soldiers injured at Fort Stewart in Georgia Wednesday.